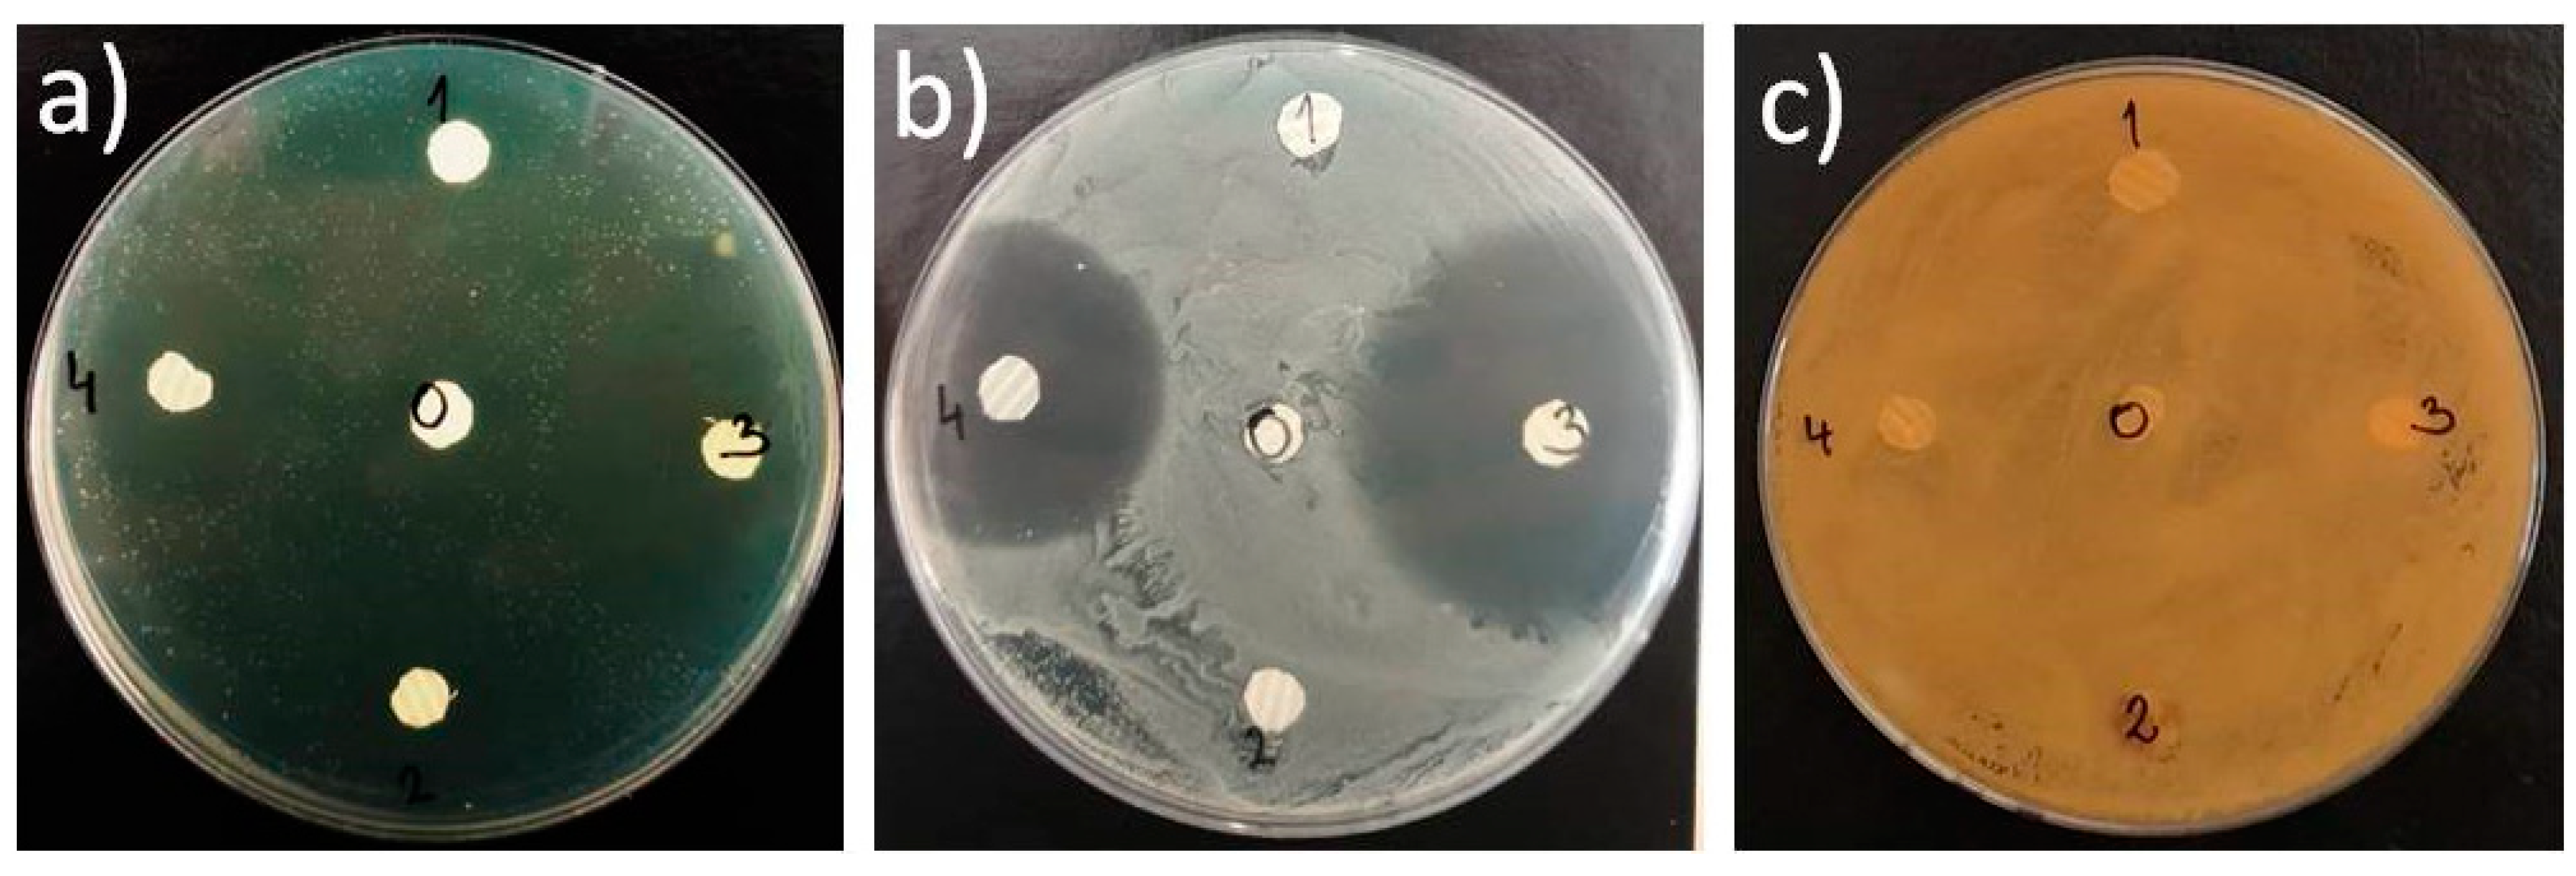

Poly(ε-caprolactone) Titanium Dioxide and Cefuroxime Antimicrobial Scaffolds for Cultivation of Human Limbal Stem Cells
Abstract
1. Introduction
2. Materials and Methods
2.1. Materials and Polymer Solution Preparation
2.2. Electrospun Scaffolds Fabrication and Post-Processing
2.3. Characterization of the Electrospun Scaffolds
2.3.1. SEM Analysis and Porosity Calculation
2.3.2. Water Contact Angle Measurement
2.3.3. Tensile Testing
2.3.4. Dynamic Mechanical Analysis
2.4. Antimicrobial Activity of the Electrospun Scaffolds
UV-Vis Spectroscopy—Active Components Release Profiles
2.5. Human LSCs Culture and Characterization on the Electrospun Scaffolds
2.5.1. Preparation of 3T3 Feeder Layer
2.5.2. Isolation and Cultivation of the LSCs
2.5.3. Immunocytochemistry and Confocal Imaging of the LSCs Cultured on the Electrospun Scaffolds
2.5.4. Metabolic Activity of the LSCs on the Electrospun Scaffolds
2.5.5. Statistical Analysis
3. Results
3.1. Electrospun Scaffolds Morphology and Total Porosity
3.2. Electrospun Scaffolds Surface Wettability
3.3. Tensile Properties of the Electrospun Scaffolds
3.4. Viscoelastic Properties of the Electrospun Scaffolds
3.5. Antimicrobial Efficiency of CF and TiO2 Components in the Electrospun Scaffolds
3.6. Evaluation of the Antimicrobial Components Release Profiles
3.7. SEM Analysis and Metabolic Activity of the LSCs on the Electrospun Scaffolds
3.8. Immunocytochemistry (ICC) of the LSCs Cultured on the Electrospun Scaffolds
4. Discussion
5. Conclusions
Author Contributions
Funding
Conflicts of Interest
References
- Giedraitis, A.; Arnoczky, S.P.; Bedi, A. Allografts in Soft Tissue Reconstructive Procedures. Sports Health A Multidiscip. Approach 2014, 6, 256–264. [Google Scholar] [CrossRef] [PubMed]
- Langer, R.; Vacanti, J.P. Tissue Engineering. Science 1993, 260, 920–926. [Google Scholar] [CrossRef] [PubMed]
- Vacanti, C.A. History of Tissue Engineering and a Glimpse into Its Future. Tissue Eng. 2006, 12, 1137–1142. [Google Scholar] [CrossRef] [PubMed]
- Zafar, M.S.; Khurshid, Z.; Almas, K. Oral tissue engineering progress and challenges. Tissue Eng. Regen. Med. 2015, 12, 387–397. [Google Scholar] [CrossRef]
- Castells-Sala, C.; Alemany-Ribes, M.; Fernández-Muiños, T.; Recha-Sancho, L.; López-Chicón, P.; Aloy-Reverté, C.; Caballero-Camino, J.; Márquez-Gil, A.; Semino, C.E. Current applications of tissue engineering in biomedicine. J. Biochips. Tiss. Chip. 2013, 1. [Google Scholar] [CrossRef]
- O’Brien, F.J. Biomaterials & scaffolds for tissue engineering. Mater. Today 2011, 14, 88–95. [Google Scholar]
- Kirkpatrick, C.J. Modelling the regenerative niche: A major challenge in biomaterials research. Regen. Biomater. 2015, 2, 267–272. [Google Scholar] [CrossRef]
- Boehler, R.M.; Graham, J.G.; Shea, L.D. Tissue engineering tools for modulation of the immune response. Biotechniques 2011, 51, 239–254. [Google Scholar] [CrossRef]
- Stratakis, E. Novel Biomaterials for Tissue Engineering 2018. Int. J. Mol. Sci. 2018, 19, 3960. [Google Scholar] [CrossRef]
- Ahadian, S.; Khademhosseini, A. Smart scaffolds in tissue regeneration. Regen. Biomater. 2018, 5, 125–128. [Google Scholar] [CrossRef]
- Woodruff, M.A.; Hutmacher, D.W. The return of a forgotten polymer—Polycaprolactone in the 21st century. Prog. Polym. Sci. 2010, 35, 1217–1256. [Google Scholar] [CrossRef]
- Mondal, D.; Griffith, M.; Venkatraman, S.S. Polycaprolactone-Based biomaterials for tissue engineering and drug delivery: Current scenario and challenges. Int. J. Polym. Mater. 2016, 65, 255–265. [Google Scholar] [CrossRef]
- Jabur, A.R.; Al-Hassani, E.; Al-Shammari, A.M.; Najim, M.A.; Hassan, A.A.; Ahmed, A.A. Evaluation of Stem Cells’ Growth on Electrospun Polycaprolactone (PCL) Scaffolds Used for Soft Tissue Applications. Energy Procedia 2017, 119, 61–71. [Google Scholar] [CrossRef]
- Labet, M.; Thielemans, W. Synthesis of polycaprolactone: A review. Chem. Soc. Rev. 2009, 38, 3484–3504. [Google Scholar] [CrossRef] [PubMed]
- Jenkins, M.; Harrison, K.L. The effect of molecular weight on the crystallization kinetics of polycaprolactone. Polym. Adv. Technol. 2006, 17, 474–478. [Google Scholar] [CrossRef]
- Zdraveva, E.; Fang, J.; Mijovic, B.; Lin, T. Electrospun nanofibers. In Structure and Properties of High-Performance Fibers; Elsevier: Amsterdam, The Netherlands, 2017; pp. 267–300. [Google Scholar]
- Qasim, S.; Zafar, M.S.; Najeeb, S.; Khurshid, Z.; Shah, A.; Husain, S.; Rehman, I.U. Electrospinning of Chitosan-Based Solutions for Tissue Engineering and Regenerative Medicine. Int. J. Mol. Sci. 2018, 19, 407. [Google Scholar] [CrossRef]
- Ko, E.; Lee, J.S.; Kim, H.; Yang, S.Y.; Yang, D.; Yang, K.; Lee, J.; Shin, J.; Yang, H.S.; Ryu, W.; et al. Electrospun Silk Fibroin Nanofibrous Scaffolds with Two-Stage Hydroxyapatite Functionalization for Enhancing the Osteogenic Differentiation of Human Adipose-Derived Mesenchymal Stem Cells. ACS Appl. Mater. Interfaces 2017, 10, 7614–7625. [Google Scholar] [CrossRef]
- Dhand, C.; Ong, S.T.; Dwivedi, N.; Diaz, S.M.; Venugopal, J.R.; Navaneethan, B.; Fazil, M.H.; Liu, S.; Seitz, V.; Wintermantel, E.; et al. Bio-Inspired in situ crosslinking and mineralization of electrospun collagen scaffolds for bone tissue engineering. Biomaterials 2016, 104, 323–338. [Google Scholar] [CrossRef]
- Zafar, M.S.; Najeeb, S.; Khurshid, Z.; Vazirzadeh, M.; Zohaib, S.; Najeeb, B.; Sefat, F. Potential of Electrospun Nanofibers for Biomedical and Dental Applications. Materials 2016, 9, 73. [Google Scholar] [CrossRef]
- Fang, J.; Wang, X.; Li, T. Functional Applications of Electrospun Nanofibers. Nanofibers Prod. Prop. Funct. Appl. 2011, 14, 287–302. [Google Scholar]
- Mijović, B.; Trcin, M.T.; Agić, A.; Zdraveva, E.; Bujic, M.; Špoljarić, I.; Kosec, V. Study on Cell Adhesion Detection onto Biodegradable Electrospun PCL Scaffolds. J. Fiber Bioeng. Inform. 2012, 5, 33–40. [Google Scholar] [CrossRef]
- Mijovic, B.; Zdraveva, E.; Bajsić, E.G.; Slivac, I.; Dekaris, I.; Grgurić, T.H.; Ferri, T.Z. Study of the Properties and Cells Growth on Antibacterial Electrospun Polycaprolactone/Cefuroxime Scaffolds. Autex Res. J. 2019, 1. [Google Scholar] [CrossRef]
- Bajsić, E.G.; Zdraveva, E.; Mijović, B.; Grgurić, T.H.; Trcin, M.T.; Ferri, T.Z. Elektroispredeni polikaprolakton za kontrolirani prijenos lijekova. Kem. Ind. 2019, 68. [Google Scholar] [CrossRef]
- Zdraveva, E.; Mijović, B.; Bajsić, E.G.; Slivac, I.; Grgurić, T.H.; Tomljenović, A.; Ferri, T.Z.; Ujčić, M. Electrospun PCL/cefuroxime scaffolds with custom tailored topography. J. Exp. Nanosci. 2019, 14, 41–55. [Google Scholar] [CrossRef]
- Grgurić, T.H.; Mijović, B.; Zdraveva, E.; Bajsić, E.G.; Slivac, I.; Ujčić, M.; Dekaris, I.; Trcin, M.T.; Vuković, A.; Kuzmić, S.; et al. Electrospinning of PCL/CEFUROXIM® fibrous scaffolds on 3D printed collectors. J. Text. Inst. 2020, 12. [Google Scholar] [CrossRef]
- Kim, J.I.; Kim, J.Y.; Park, C.H. Fabrication of transparent hemispherical 3D nanofibrous scaffolds with radially aligned patterns via a novel electrospinning method. Sci. Rep. 2018, 8, 1–13. [Google Scholar]
- Gao, Q.; Gu, H.; Zhao, P.; Zhang, C.; Cao, M.; Fu, J.; He, Y. Fabrication of electrospun nanofibrous scaffolds with 3D controllable geometric shapes. Mater. Des. 2018, 157, 159–169. [Google Scholar] [CrossRef]
- Zhou, Y.; Hu, Z.; Du, D.; Tan, G.Z. The effects of collector geometry on the internal structure of the 3D nanofiber scaffold fabricated by divergent electrospinning. Int. J. Adv. Manuf. Technol. 2018, 100, 3045–3054. [Google Scholar] [CrossRef]
- Kodym, A.; Wiśniewski, A.; Knioła, D.; Olejniczak, M. Stability of cefuroxime in 1% and 5% buffered eye drops determined with HPLC method. Acta Pol. Pharm. Drug Res. 2011, 68, 555–564. [Google Scholar]
- Orlans, H.O.; Hornby, S.J.; Bowler, I.C.J.W. In Vitro antibiotic susceptibility patterns of bacterial keratitis isolates in Oxford, UK: A 10-year review. Eye 2011, 25, 489. [Google Scholar] [CrossRef]
- Miyake, H.; Miyazaki, D.; Shimizu, Y.; Sasaki, S.-I.; Baba, T.; Inoue, Y.; Matsuura, K. Toxicities of and inflammatory responses to moxifloxacin, cefuroxime, and vancomycin on retinal vascular cells. Sci. Rep. 2019, 9, 9745. [Google Scholar] [CrossRef] [PubMed]
- Pfaff, G.; Reynders, P. Angle-Dependent Optical Effects Deriving from Submicron Structures of Films and Pigments. Chem. Rev. 1999, 99, 1963–1982. [Google Scholar] [CrossRef] [PubMed]
- Salvador, A.; Pascual-Martí, M.C.; Adell, J.R.; Requeni, A.; March, J.G. Analytical methodologies for atomic spectrometric determination of metallic oxides in UV sunscreen creams. J. Pharm. Biomed. Anal. 2000, 22, 301–306. [Google Scholar] [CrossRef]
- Nygren, H.; Tengvall, P.; Lundström, I. The initial reactions of TiO2 with blood. J. Biomed. Mater. Res. A 1997, 34, 487–492. [Google Scholar] [CrossRef]
- Ikono, R.; Li, N.; Pratama, N.H.; Vibriani, A.; Yuniarni, D.R.; Luthfansyah, M.; Bachtiar, B.M.; Bachtiar, E.W.; Mulia, K.; Nasikin, M.; et al. Enhanced bone regeneration capability of chitosan sponge coated with TiO2 nanoparticles. Biotechnol. Rep. 2019, 24, e00350. [Google Scholar] [CrossRef]
- Haugen, H.; Lyngstadaas, S. Antibacterial effects of titanium dioxide in wounds. In Wound Healing Biomaterials; Elsevier: Amsterdam, The Netherlands, 2016; pp. 439–450. [Google Scholar]
- How Does The Human Eye Work? Available online: https://www.nkcf.org/about-keratoconus/how-the-human-eye-works/ (accessed on 12 September 2019).
- Gonzalez, G.; Sasamoto, Y.; Ksander, B.R.; Frank, M.H.; Frank, N.Y. Limbal stem cells: Identity, developmental origin, and therapeutic potential. Wiley Interdiscip. Rev. Dev. Biol. 2018, 7, e303. [Google Scholar] [CrossRef]
- Fernandez-Buenaga, R.; Aiello, F.; Zaher, S.S.; Grixti, A.; Ahmad, S. Twenty years of limbal epithelial therapy: An update on managing limbal stem cell deficiency. BMJ Open Ophthalmol. 2018, 3, e000164. [Google Scholar] [CrossRef]
- Behaegel, J.; Ni Dhubhghaill, S.; Koppen, C.; Zakaria, N. Safety of Cultivated Limbal Epithelial Stem Cell Transplantation for Human Corneal Regeneration. Stem Cells Int. 2017, 2017, 1–11. [Google Scholar] [CrossRef]
- Balan, K.K.; Sivanesan, V.; Moorthy, N.; Budhhan, D.; Jeyaseelan, S.; Sundaramoorthy, S. Effect of thickness of mat and testing parameters on tensile strength variability of electrospun nanofibrous mat. Mater. Today: Proc. 2016, 3, 1320–1329. [Google Scholar] [CrossRef]
- Stalder, A.F.; Melchior, T.; Müller, M.; Sage, D.; Blu, T.; Unser, M. Low-Bond axisymmetric drop shape analysis for surface tension and contact angle measurements of sessile drops. Colloids Surfaces A Physicochem. Eng. Asp. 2010, 364, 72–81. [Google Scholar] [CrossRef]
- Sheng, D.; Li, J.; Ai, C.; Feng, S.; Ying, T.; Liu, X.; Cai, J.; Ding, X.; Jin, W.; Xu, H.; et al. Electrospun PCL/Gel-aligned scaffolds enhance the biomechanical strength in tendon repair. J. Mater. Chem. B 2019, 7, 4801–4810. [Google Scholar] [CrossRef] [PubMed]
- Arbade, G.K.; Kumar, V.; Tripathi, V.; Menon, A.; Bose, S.; Patro, T.U. Emblica officinalis-loaded poly(ε-caprolactone) electrospun nanofiber scaffold as potential antibacterial and anticancer deployable patch. New J. Chem. 2019, 43, 7427–7440. [Google Scholar] [CrossRef]
- Lee, W.S.; Park, Y.-S.; Cho, Y.-K. Significantly enhanced antibacterial activity of TiO2 nanofibers with hierarchical nanostructures and controlled crystallinity. Analyst 2015, 140, 616–622. [Google Scholar] [CrossRef]
- Fernández-Pérez, J.; Kador, K.E.; Lynch, A.P.; Ahearne, M. Characterization of extracellular matrix modified poly(ε-caprolactone) electrospun scaffolds with differing fiber orientations for corneal stroma regeneration. Mater. Sci. Eng. C 2020, 108, 110415. [Google Scholar] [CrossRef]
- Hu, J.; Prabhakaran, M.P.; Tian, L.; Ding, X.; Ramakrishna, S. Drug-Loaded emulsion electrospun nanofibers: Characterization, drug release and in vitro biocompatibility. RSC Adv. 2015, 5, 100256–100267. [Google Scholar] [CrossRef]
- Qian, Y.; Zhang, Z.; Zheng, L.; Song, R.; Zhao, Y. Fabrication and Characterization of Electrospun Polycaprolactone Blended with Chitosan-Gelatin Complex Nanofibrous Mats. J. Nanomater. 2014, 2014, 1–7. [Google Scholar] [CrossRef]
- Sanie-Jahromi, F.; Eghtedari, M.; Mirzaei, E.; Jalalpour, M.H.; Asvar, Z.; Nejabat, M.; Javidi-Azad, F. Propagation of limbal stem cells on polycaprolactone and polycaprolactone/gelatin fibrous scaffolds and transplantation in animal model. BioImpacts 2019, 10, 45–54. [Google Scholar] [CrossRef]
- Rose, J.B.; Sidney, L.E.; Patient, J.; White, L.J.; Dua, H.S.; El Haj, A.J.; Hopkinson, A.; Rose, F.R. In Vitro evaluation of electrospun blends of gelatin and PCL for application as a partial thickness corneal graft. J. Biomed. Mater. Res. Part A 2019, 107, 828–838. [Google Scholar] [CrossRef]
- Fu, W.; Liu, Z.; Feng, B.; Hu, R.; He, X.; Wang, H.; Yin, M.; Huang, H.; Zhang, H.; Wang, W. Electrospun gelatin/PCL and collagen/PLCL scaffolds for vascular tissue engineering. Int. J. Nanomed. 2014, 9, 2335–2344. [Google Scholar] [CrossRef]
- Wu, J.; Du, Y.; Watkins, S.C.; Funderburgh, J.L.; Wagner, W.R. The engineering of organized human corneal tissue through the spatial guidance of corneal stromal stem cells. Biomaterials 2012, 33, 1343–1352. [Google Scholar] [CrossRef]
- Sack, R.A.; Nunes, I.; Beaton, A.; Morris, C. Host-Defense Mechanism of the Ocular Surfaces. Biosci. Rep. 2001, 21, 463–480. [Google Scholar] [CrossRef]
- McLaughlin, C.R.; Tsai, R.J.-F.; Latorre, M.A.; Griffith, M. Bioengineered corneas for transplantation and in vitro toxicology. Front. Biosci. 2009, 14, 3326–3337. [Google Scholar] [CrossRef]
- Johnson, C.D.; D’Amato, A.R.; Gilbert, R.J. Electrospun Fibers for Drug Delivery after Spinal Cord Injury and the Effects of Drug Incorporation on Fiber Properties. Cells Tissues Organs 2016, 202, 116–135. [Google Scholar] [CrossRef]
- Chen, Y.-P.; Liu, H.-Y.; Liu, Y.-W.; Lee, T.-Y.; Liu, S.-J. Determination of Electrospinning Parameters’ Strength in Poly(D,L)-lactide-co-glycolide Micro/Nanofiber Diameter Tailoring. J. Nanomater. 2019, 2019, 1–8. [Google Scholar] [CrossRef]
- O’Brien, F.J.; Harley, B.A.; Waller, M.A.; Yannas, I.V.; Gibson, L.J.; Prendergast, P.J. The effect of pore size on permeability and cell attachment in collagen scaffolds for tissue engineering. Technol. Health Care 2007, 15, 3–17. [Google Scholar] [CrossRef]
- Chew, S.Y.; Hufnagel, T.C.; Lim, C.T.; Leong, K.W. Mechanical properties of single electrospun drug-encapsulated nanofibres. Nanotechnology 2006, 17, 3880. [Google Scholar] [CrossRef]
- Reid, J.A.; Callanan, A. Influence of aorta extracellular matrix in electrospun polycaprolactone scaffolds. J. Appl. Polym. Sci. 2019, 136, 48181. [Google Scholar] [CrossRef]
- Zeng, Y.-J.; Yang, J.; Huang, K.; Lee, Z.; Lee, X. A comparison of biomechanical properties between human and porcine cornea. J. Biomech. 2001, 34, 533–537. [Google Scholar] [CrossRef]
- Zhu, X.; Cui, W.; Li, X.; Jin, Y. Electrospun Fibrous Mats with High Porosity as Potential Scaffolds for Skin Tissue Engineering. Biomacromolecules 2008, 9, 1795–1801. [Google Scholar] [CrossRef]
- Dalgic, A.D.; Atila, D.; Karatas, A.; Tezcaner, A.; Keskin, D. Diatom shell incorporated PHBV/PCL-pullulan co-electrospun scaffold for bone tissue engineering. Mater. Sci. Eng. C 2019, 100, 735–746. [Google Scholar] [CrossRef]
- Vieille, B.; Albouy, W.; Chevalier, L.; Taleb, L. About the influence of stamping on thermoplastic-based composites for aeronautical applications. Compos. Part. B Eng. 2013, 45, 821–834. [Google Scholar] [CrossRef]
- Foraida, Z.I.; Kamaldinov, T.; Nelson, D.; Larsen, M.; Castracane, J. Elastin-PLGA hybrid electrospun nanofiber scaffolds for salivary epithelial cell self-organization and polarization. Acta Biomater. 2017, 62, 116–127. [Google Scholar] [CrossRef]
- Trcin, M.T.; Dekaris, I.; Mijović, B.; Bujic, M.; Zdraveva, E.; Dolenec, T.; Pauk-Gulić, M.; Primorac, A.; Crnjac, J.; Spoljaric, B.; et al. Synthetic vs natural scaffolds for human limbal stem cells. Croat. Med. J. 2015, 56, 246–256. [Google Scholar] [CrossRef]
- Pellegrini, G.; Rama, P.; Matuska, S.; Lambiase, A.; Bonini, S.; Pocobelli, A.; Colabelli, R.G.; Spadea, L.; Fasciani, R.; Balestrazzi, E.; et al. Biological parameters determining the clinical outcome of autologous cultures of limbal stem cells. Regen. Med. 2013, 8, 553–567. [Google Scholar] [CrossRef]
- Maleki, H.; Gharehaghaji, A.A.; Toliyat, T.; Dijkstra, P.J. Drug release behavior of electrospun twisted yarns as implantable medical devices. Biofabrication 2016, 8, 035019. [Google Scholar] [CrossRef]
- Ortega, Í.; Ryan, A.J.; Deshpande, P.; MacNeil, S.; Claeyssens, F. Combined microfabrication and electrospinning to produce 3-D architectures for corneal repair. Acta Biomater. 2013, 9, 5511–5520. [Google Scholar] [CrossRef]
- Rama, P.; Matuska, S.; Paganoni, G.; Spinelli, A.; De Luca, M.; Pellegrini, G. Limbal Stem-Cell Therapy and Long-Term Corneal Regeneration. Engl. J. Med. 2010, 363, 147–155. [Google Scholar] [CrossRef]

| Electrospun Scaffolds | Measured Water Contact Angles(◦) | |
|---|---|---|
| 1 s | 3–5 s | |
| PCL | 117.8 ± 4.4 | 117.8 ± 4.4 |
| PCL/n-TiO2 | 123.8 ± 2.6 | 122.6 ± 3.9 |
| PCL/m-TiO2 | 124.4 ± 7.7 | 122.9 ± 5.0 |
| PCL/5 wt % CF | 112.0 ± 5.4 | 86.7 ± 16.1 |
| PCL/25 wt % CF | - | - |
| Electrospun Scaffolds | Fmax (N) | ɛ (%) | σ (N/mm2) |
|---|---|---|---|
| PCL | 5.66 ± 1.40 | 169.50 ± 26.15 | 3.41 ± 0.84 |
| PCL/5 wt % CF | 0.72 ± 0.09 | 38.50 ± 3.77 | 0.68 ± 0.09 |
| PCL/25 wt % CF | 5.03 ± 0.51 | 364.00 ± 32.32 | 3.53 ± 0.34 |
| PCL/n-TiO2 | 4.22 ± 0.33 | 110.00 ± 9.04 | 2.58 ± 0.20 |
| PCL/m-TiO2 | 4.08 ± 0.25 | 150.50 ± 12.12 | 2.52 ± 0.15 |
| Inhibition Zone (mm) | ||||
|---|---|---|---|---|
| Electrospun Scaffold | Label | P. aeruginosa | S. aureus | C. albicans |
| PCL | 0 | n.p. | n.p. | n.p. |
| PCL/5 wt % CF | 4 | 27.0 ± 1.41 | 31.0 ± 1.41 | n.p. |
| PCL/25 wt % CF | 3 | 40.5 ± 0.71 | 44.0 ± 1.41 | n.p. |
| PCL/n-TiO2 | 2 | 18.5 ± 2.12 | n.p. | n.p. |
| PCL/m-TiO2 | 1 | n.p. | n.p. | n.p. |
© 2020 by the authors. Licensee MDPI, Basel, Switzerland. This article is an open access article distributed under the terms and conditions of the Creative Commons Attribution (CC BY) license (http://creativecommons.org/licenses/by/4.0/).
Share and Cite
Tominac Trcin, M.; Zdraveva, E.; Dolenec, T.; Vrgoč Zimić, I.; Bujić Mihica, M.; Batarilo, I.; Dekaris, I.; Blažević, V.; Slivac, I.; Holjevac Grgurić, T.; et al. Poly(ε-caprolactone) Titanium Dioxide and Cefuroxime Antimicrobial Scaffolds for Cultivation of Human Limbal Stem Cells. Polymers 2020, 12, 1758. https://doi.org/10.3390/polym12081758
Tominac Trcin M, Zdraveva E, Dolenec T, Vrgoč Zimić I, Bujić Mihica M, Batarilo I, Dekaris I, Blažević V, Slivac I, Holjevac Grgurić T, et al. Poly(ε-caprolactone) Titanium Dioxide and Cefuroxime Antimicrobial Scaffolds for Cultivation of Human Limbal Stem Cells. Polymers. 2020; 12(8):1758. https://doi.org/10.3390/polym12081758
Chicago/Turabian StyleTominac Trcin, Mirna, Emilija Zdraveva, Tamara Dolenec, Ivana Vrgoč Zimić, Marina Bujić Mihica, Ivanka Batarilo, Iva Dekaris, Valentina Blažević, Igor Slivac, Tamara Holjevac Grgurić, and et al. 2020. "Poly(ε-caprolactone) Titanium Dioxide and Cefuroxime Antimicrobial Scaffolds for Cultivation of Human Limbal Stem Cells" Polymers 12, no. 8: 1758. https://doi.org/10.3390/polym12081758
APA StyleTominac Trcin, M., Zdraveva, E., Dolenec, T., Vrgoč Zimić, I., Bujić Mihica, M., Batarilo, I., Dekaris, I., Blažević, V., Slivac, I., Holjevac Grgurić, T., Bajsić, E. G., Markov, K., Čanak, I., Kuzmić, S., Tarbuk, A., Tomljenović, A., Mrkonjić, N., & Mijović, B. (2020). Poly(ε-caprolactone) Titanium Dioxide and Cefuroxime Antimicrobial Scaffolds for Cultivation of Human Limbal Stem Cells. Polymers, 12(8), 1758. https://doi.org/10.3390/polym12081758

